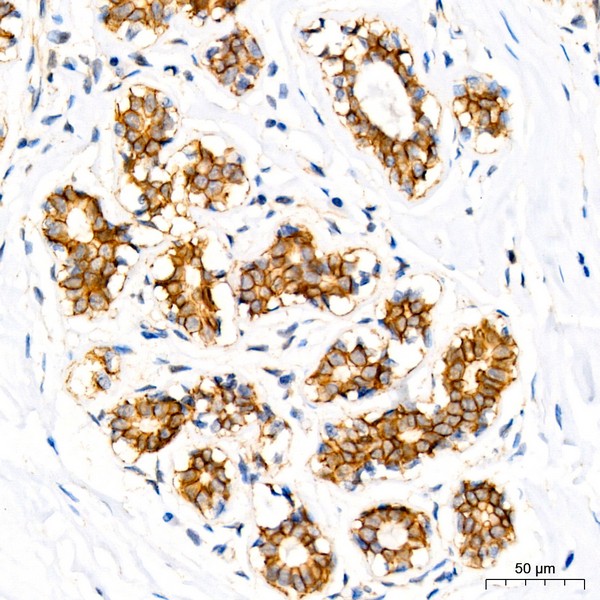
A11399: δ-Catenin/p120 Catenin Rabbit mAb

δ-Catenin/p120 Catenin Rabbit mAb (A11399)
$148.00 – $548.00
Abclonal δ-Catenin/p120 Catenin Rabbit mAb (Catalog Number: A11399) encodes a member of the Armadillo protein family, which function in adhesion between cells and signal transduction.
- Details & Specifications
- References
| Catalog No. | A11399 |
|---|---|
| Product Name | δ-Catenin/p120 Catenin Rabbit mAb (A11399) |
| Supplier Name | ABclonal, Inc. |
| Brand Name | Abclonal |
| Synonyms | CAS; p120; BCDS2; CTNND; P120CAS; P120CTN; p120(CAS); p120(CTN) |
| Summary | Rabbit IgG polyclonal antibody for AQP11 detection. Tested with WB, FCM, Direct ELISA in Human;Mouse;Rat. |
| Gene Name | CTNND1 |
| Gene Full Name | aquaporin 11 |
| Protein Name | CTNND1 |
| Uniprot/Swissprot ID | O60716 |
| Uniprot ID | Q8NBQ7 |
| Gene ID | 1500 |
| Clone | ARC0586 |
| Clonality | Monoclonal |
| Source/Host | Rabbit |
| Application Details | Western blot|0.25-0.5 μg/ml|Human, Mouse, Rat| Flow Cytometry|1-3 μg/1x10^6 cells|Human| Direct ELISA|0.1-0.5 μg/ml|Human| |
| Reactivity | Human, Mouse, Rat |
| Immunogen | E.coli-derived human AQP11 recombinant protein (Position: L30-L57). |
| Purification | Immunogen affinity purified. |
| Form Of Antibody | Lyophilized |
| Reconstitution | Adding 0.2 ml of distilled water will yield a concentration of 500 μg/ml. |
| Contents | E.coli-derived human AQP11 recombinant protein (Position: L30-L57). |
| Conjugate | Unconjugated |
| Stability & Storage | At -20˚C for one year from date of receipt. After reconstitution, at 4˚C for one month. It can also be aliquotted and stored frozen at -20˚C for six months. Avoid repeated freezing and thawing. |
| Note | Products will be shipped from the warehouse in Massachusetts. Promotion is running from time to time. Welcome to send a request for quote to message@sydlabs.com. |
| Order Offline | Syd Labs, Inc. 4 Avenue E, Hopkinton, MA 01748 USA. Phone: 1-617-401-8149 Fax: 1-617-606-5019 Email: message@sydlabs.com |
Description
A11399: δ-Catenin/p120 Catenin Rabbit mAb
This gene encodes a member of the Armadillo protein family, which function in adhesion between cells and signal transduction. Multiple translation initiation codons and alternative splicing result in many different isoforms being translated. Not all of the full-length natures of the described transcript variants have been determined. Read-through transcription also exists between this gene and the neighboring upstream thioredoxin-related transmembrane protein 2 (TMX2) gene.
Immunogen Information about δ-Catenin/p120 Catenin Rabbit mAb (A11399)
Immunogen:A synthetic peptide corresponding to a sequence within amino acids 869-968 of human δ-Catenin/p120 Catenin (O60716).
Sequence:TLPLIDRNQKSDKKPDREEIQMSNMGSNTKSLDNNYSTPNERGDHNRTLDRSGDLGDMEPLKGTTPLMQDEGQESLEEELDVLVLDDEGGQVSYPSMQKI
Gene ID:1500
Swiss prot:O60716
Synonyms:CAS; p120; BCDS2; CTNND; P120CAS; P120CTN; p120(CAS); p120(CTN); δ-Catenin/p120 Catenin
Calculated MW:108kDa
Observed MW:100kDa/110kDa
Images of δ-Catenin/p120 Catenin Rabbit mAb (A11399)

Western blot analysis of various lysates using δ-Catenin/p120 Catenin Rabbit mAb (A11399) at 1:1000 dilution.
Secondary antibody: HRP Goat Anti-Rabbit IgG (H+L) (AS014) at 1:10000 dilution.
Lysates/proteins: 25μg per lane.
Blocking buffer: 3% nonfat dry milk in TBST.
Detection: ECL Basic Kit (RM00020).
Exposure time: 3min.

Immunohistochemistry analysis of δ-Catenin/p120 Catenin in paraffin-embedded human breast using δ-Catenin/p120 Catenin Rabbit mAb (A11399) at dilution of 1:100 (40x lens).Perform high pressure antigen retrieval with 10 mM Tris/EDTA buffer pH 9.0 before commencing with IHC staining protocol.

Immunohistochemistry analysis of δ-Catenin/p120 Catenin in paraffin-embedded human placenta using δ-Catenin/p120 Catenin Rabbit mAb (A11399) at dilution of 1:100 (40x lens).Perform high pressure antigen retrieval with 10 mM Tris/EDTA buffer pH 9.0 before commencing with IHC staining protocol.

Immunoprecipitation analysis of 600 μg extracts of Mouse testis cells using 3 μg δ-Catenin/p120 Catenin antibody (A11399). Western blot was performed from the immunoprecipitate using δ-Catenin/p120 Catenin antibody (A11399) at a dilution of 1:1000.
Please remember our product information: δ-Catenin/p120 Catenin Rabbit mAb (Catalog Number: A11399) Abclonal